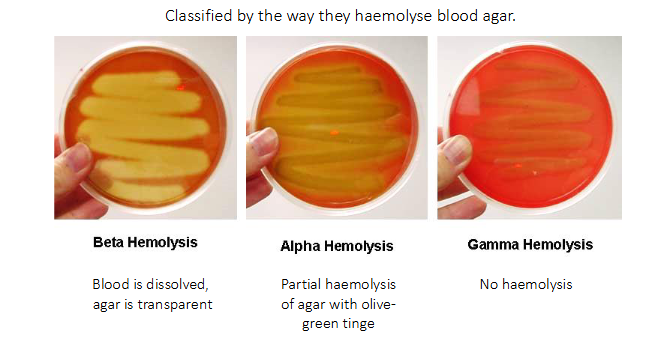
<p>- Classified by the way they haemolyse blood agar</p><p>.</p><p>BETA HAEMOLYSIS:</p><p>- blood is dissolved, agar is transparent</p><p>.</p><p>ALPHA HAEMOLYSIS:</p><p>- partial haemolysis of agar with olive-green tinge</p><p>.</p><p>GAMMA HAEMOLYSIS:</p><p>- No haemolysis</p>

IMED2001 - Medically important Gram Positive Cocci (L3)
1/28
There's no tags or description
Looks like no tags are added yet.
Name | Mastery | Learn | Test | Matching | Spaced | Call with Kai |
|---|
No analytics yet
Send a link to your students to track their progress
29 Terms

stages of infection DIAGRAM
- two ways to infect: the actual pathogen invades or the toxins cause disease


A working scheme for classification of medically important bacteria
DIAGRAM ON SLIDE 4


Classification of Medically important gram-positive bacteria
DIAGRAM ON SLIDE 6


Focused more on cocci classification of medically important gram-positive bacteria
- lecture focus on streptococcus and staphylococcus
- notice that all aerobes are cocci or bacilli
- then we have catalase and coagulase tests


Catalase Reaction
- Staphylococci produce catalase enzyme: H2O2 <--> H2O + O2
- Catalase positive: bubbling
- Catalase negative: no bubbling

Coagulase positive staphylococci are
usually Staph aureus

Coagulase Test for Staphylococci
- what we do is we get plasma (left from spinning blood to be left with plasma) and if we add Staph aureus culture to the plasma the coagulase enzyme which is present in Staph aureus coagulates the plasma and you get a little clot
- forms a little clot within and it activates the clotting cascadde in the plasma
.
- coagulase negative staphylococci shows that plasma spreads over the test tube


The Genus Staphylococcus
- Coagulase negative staphylococci: most are memberes of normal skin flora of humans
.
- dont need to know all the names
- Low virulence, but pathogenic in some settings (typically when skin barrier has been breached, e.g by invasive devices, premature infants
- Vary in pathogenic potential


Staphylococcus Aureus
- 20-40% of population are carriers (anterior nares (nostrils), skin of the axilla and groin)
- May cause localised or disseminated infections
- Pyogenic (pus forming, e.g abscess) infections in almost any organ (coagulase toxin 'walls off' infection, while lytic toxins (haemolysins, proteases) destroy tissue


S. aureus: what determines colonisation vs disease (Basically why is it that so many of us are asymptomatically colonised by S. aureus whereas others develop disease)
Staphylococcal Quorum Sensing
.
- Quorum Sensing (QS): chemical communication between bacteria that depends on the surrounding environmental conditions, including bacterial density
- Influences bacterial behaviour, allowing bacteria to collaborate in response to environmental conditions
- The quorum sensing system in Staphylococcus aureus works through the accessory gene regulator (agr)
- Agr contributes to S. aureus pathogenicity in several infection types, including subcutaneous abscesses, endocarditis and arthritis
.
- basically it responds to the environment that allows it to behave in a certain way in its environment


The staphylococcal quorum sensing system
- The agr-sensing system is an auto-activating circuit (details not for exam purposes)


Staphylococcus Aureus Infections
- Frequent cause of skin infections
.
- Folliculitis
- Furuncles (boils)
- Carbuncles
- Impetigo
- Cellulitis
- Wound Infections


Staphylococcus Aureus Infections (other localised infections)
- Lung abscess
- Brain abscess (means swelling due to pus)
- Mastitis
.
- Disseminated infection - bacteraemia
- S. aureus circulating in the bloodstream
- May progress to infection of a heart valve: endocarditis

Staphylococcus Aureus Toxins
Some toxin-producing stains of S. aureus can cause non-pyogenic disease:
- Staphylococcal scalded skin syndrome (SSSS)
- Staphylococcal toxic shock syndrome (STSS)
- Staphylococcal food poisoning

Staphylococcus Aureus Superantigens
STAPHYLOCOCCAL SCALDED SKIN SYNDROME (SSSS):
- caused by an enterotoxin, the gene fore which which originated in a bacteriophage (acquired by transduction)
- The enterotoxin is a 'superantigen'
- Superantigens bypass normal antigen presentation by directly crosslinking T cell receptor and MCH II
- causes polyclonal activation of T cells and an inflammatory cascade
.
- essentially it causes an inappropriate immune response, hence inflammation


The genus Streptococcus (and Enterococcus)
- Classified by the way they haemolyse blood agar
.
BETA HAEMOLYSIS:
- blood is dissolved, agar is transparent
.
ALPHA HAEMOLYSIS:
- partial haemolysis of agar with olive-green tinge
.
GAMMA HAEMOLYSIS:
- No haemolysis

The Beta-haemolytic streptococci
- Further classified according to antigenic differences in cell wall carbohydrates
- Lancefield grouping system: 20 different groups (A-H, K-V)
- Two lancefield groups are of particular clinical importance
.
LANCEFIELD GROUP A (= Strep A)
- also known by its species name, Streptococcus pyogenes
LANCEFIELD GROUP B
- Also known by its species name, Streptococcus agalactiae
- Colonises the urogenital tract and rectum of women, transmitted to infants during/after birth
- causes severe infections (meningitis and bloodstream infections) in neonates


Lancefield group A Beta-Haemolytic Streptococcus (Streptococcus pyogenes)
PRIMARY INFECTION:
- Throat (pharyngitis or tonsilitis) -> abscess local extension (sinuses, mastoid)
- Skin (e.g cellulitis or impetigo) -> necrotizing fasciitis (suppurative complications)


Throat Infections caused by Strep A
- Strep A is commonest bacterial cause of pharyngitis/tonsilitis ("strep throat")
- Peritonsillar abscess (quinsy)


Skin and soft tissue infections caused by Strep A
- Impetigo
- Necrotising fasciitis (rapidly spreading destructive infection)


Non-suppurative complications of Strep A infection
- non-suppurative means non-pus forming complications
- due to immune response to infection
.
PRIMARY INFECTION:
Throat or Skin infection
- as a consequence of the immune response to this infection you develop these other diseases (acute rheumatic fever or acute glomerulonephritis)
- can cause rheumatic heart disease


Lancefield group A beta-haemolytic streptococcus (Streptococcus pyogenes)
ACUTE RHEUMATIC FEVER:
- Common in aboriginal children, and worldwide associated with poverty
- Syndrome including arthritis, rash, writhing movements and carditis
.
- carditis: damage to heart valves and muscle
- recurrent rheumatic fever leads to rheumatic heart disease years later
- Chronic narrowing or stiffness of heart valves


Pathogenesis of acute rheumatic fever
- some of the proteins Strep A produces or has in its cell wall are very very similar to proteins which are found on human heart tissue
- so when you produce an antibody against the Group A streptococcal protein, it also recognises the heart protein
- and so then you get this cross reaction of the immune response, where antibodies that your body intends to kill Group A strep are instead attacking your heart tissue
- stimualtes an inflammatory cascade in your heart tissue, causing problems


The alpha-haemolytic streptococci
- common commensals of the oropharynx, nasopharynx, gut and genital tract
TWO GROUPS:
- 'viridans' group of streptococci
streptococcus mutans group (dental caries)
- Streptococcus pneumoniae


Pathogenesis of dental caries
- Continuous intake of sucrose (sugar) favours the growth of S. mutans
- S. mutans secretes glycosyltransferases (GTFs) which adsorb onto the enamel
- GTFs catabolise sucrose to produce large amounts of glucans, whcih contribute to the buildup of extracellular polysaccharide matrix which serves as a scaffold for biofilm
- Organic acids (e.g lactic acid) are produced by bacteria in the biofilm, decreasing pH
- the low pH leads to demineralisation of enamel and initiates the carious process
.
Dental caries, or tooth decay, is a prevalent chronic disease where cariogenic bacteria metabolize sugars to produce acids, causing mineral loss and structural damage to teeth. It manifests as white spots, dark stains, sensitivity, and pain. Prevention involves fluoridated toothpaste, reduced sugar intake, and brushing, while treatment includes fillings, crowns, or root canals.


Evolution of S. mutans
- The introduction of fermented foods into the human diet (due to agricultural practices and food preservation methods) put lactic acid bacteria, such as Lactobacillus and Leuconostoc, in contact with oral Streptococci
- Streptococci acquired the gtf gene via horizontal gene transfer from these lactic acid bacilli
- Selective pressure (eating sugar) resulted in selection for Streptococci strains wtih multiple copies of the gtf gene


Streptococcus pneumoniae: the pneumoccous
- Leading bacterial cause of pneumonia (most important cause of child death outside neonatal period)
- Also causes meningitis
- Gram-positive diplococcus
.
POLYSACCHARIDE CAPSULE:
- >94 distinct capsular types identified
- important pathogenic factor for invasive disease; prevents phagocytosis
- protection is specific to capsular type (serotype) - vaccines protect against specific serotypes (e.g PCV-13)


S. pneumoniae carriage
- Nasopharyngeal carriage of S. pneumoniae is necessary for transmisison of bacteira and precdes invasive disease
- Carriage is age-dependent (more common in children)


Conjugate Vaccines
- Polysaccharide vaccines (based on bacterial capsules) do not induce a strong or persistent immune response in young children
- Polysaccharides become very immunogenic when linked to a carrier protein (e.g, tetanus toxoid) = conjugate vaccine
- Importantly, conjugate vaccines induce memory responses and reduce nasopharyngeal carriage of bacteria, impacting on transmission
- Conjugate vaccines against Haemophilus influenzae type b (Hib), pneumococcus and meningococcus serogroups C, A, W, and Y have contributed to the virtual elimination of bacterial meningitis caused by these bacteria and prevent more than a million deaths annually
.
- basically it gives people memory from bacterial disease
- basically when we attach pneumococcal polysaccharides to a protein carrier, suddenly we change the way the immune system recognises this antigen
- so now what happens is you get presentation of B cells you also get presentation to T cells, and the conjugate (this portein part) is presnted in the MHC class 2 cleft, and it presents pneumococcal polysaccharide to the T cell receptor or the B cell receptor
